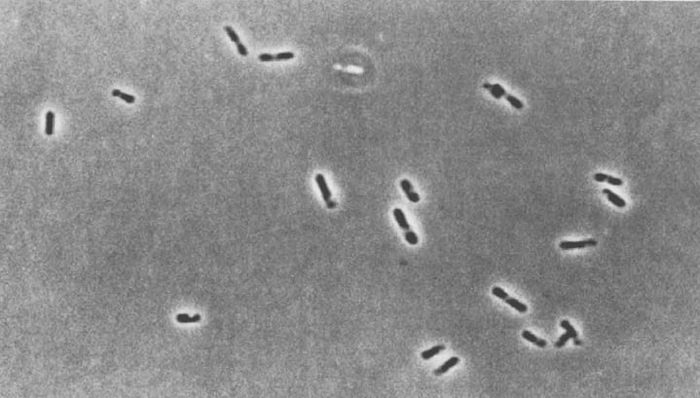

Выдающиеся крепости и замки
Самая героическая (субъективно)
Брестская крепость, Брест, Беларусь.
Легендарный бастион построен в 1842 году. Он стоит на 4 островах. Современный комплекс включает в себя развалины цитадели, уцелевшие постройки, а также крепостной вал и памятники.
Девять тысяч красноармейцев начиная с 22 июня 1941 года держали оборону, мешая активному продвижению фашистов. Советские бойцы не сдавались, несмотря на потери. После разрушения артиллерией врага большинства верхних построек они закрепились в казематах и подвалах. Выживали без еды, воду собирали со стен.
Немцы смогли захватить крепость окончательно лишь через 2 месяца, когда фронт был уже далеко на востоке.
Самый большой замок в мире
Замок Мариенбург, Мариенбург, Польша.
На правом берегу реки Ногата, недалеко от Гданьска, находится крупнейший кирпичный замок мира. Он был заложен в 1278 году тевтонским рыцарским орденом Marienburg в Мальборке и с 1308 года служил резиденцией его Великого магистра. Отсюда немецкие крестоносцы совершали свои завоевательные походы, вплоть до поражения в Грюнвальдской битве в 1410 году. После этого замок оказался в составе Королевства Польского и на протяжении следующих 300 лет служил резиденцией его правителей. Наполеон здесь размещал свой арсенал, а Гитлер использовал для паломничества юных арийцев. В 1945 году замок был практически разрушен, а позднее — полностью восстановлен по старинным чертежам и фото. В уникальном историческом сооружении можно увидеть богатую коллекцию янтаря, средневекового оружия и скульптур, витражей, монет, медалей, кованых изделий и керамики.
Самая древняя крепость в России
Цитадель «Нарын-Кала», Дербент, Россия
Возведена в Дербенте в начале IV века, когда правила персидская династия Сасанидов. Цитадель обороняла от нападок кочевников и «запирала» проливы, которые вели в Персию («Каспийские ворота»). Крепостная стена тянется на 40 км.
Туристам открыты: фрагмент ханского дворца, бани — полуподвальное помещение, зандан-тюрьма, похожая на подземный кувшин (глубина 11 м), ворота Орта-калы.
Крепость считается совершенно обязательной к осмотру ещё и из-за сногсшибательного вида на город и окрестности, который отсюда открывается.
Самый главный замок Шотландии
Эдинбургский замок, Шотландия
“Венец всего здесь скрыт. Всего лишь шаг остался. Но он – наследие для сильных или умных,- Получишь все и ничего, когда достать его сумеешь.”
С. Лукьяненко "Последний Дозор"
Самый главный замок-крепость Шотландии словно парит над городом Эдинбургом, находясь на неприступной скале. Подойти к нему можно только с восточной стороны, где столетия назад была обустроена эспланада. А теперь это улица — Королевская миля, на которой ежегодно проходит Королевский эдинбургский парад военных оркестров. Древний комплекс, впервые упомянутый в 1139 году, полностью соответствует представлениям о старинном замке — несокрушимый, с темной плотной каменной кладкой, имеющий несколько угрюмый и угрожающий вид. Древнейшая постройка на его территории — капелла Святой Маргариты. В числе самых популярных достопримечательностей — Камень судьбы, представляющий собой глыбу песчаника весом 152 кг и возрастом более 3 тыс. лет, на нем короновали многих правителей государства.
Самый монархичный замок
Виндзорский замок, Виндзор, Великобритания
Захватив Англию в 1066 году, Вильгельм I Завоеватель окружил Лондон кольцом из замков, стоящих на насыпных холмах в 30 километрах от столицы.
Первым использовал Виндзорский замок как свою резиденцию король Генрих I в 1110 году, тут же он в 1121 году женился на Аделе. К этому моменту деревянные строения частично разрушились из-за постепенного оседания холма. Тогда в холм вбили деревянные сваи, на которых возвели каменную крепость. Взошедший в 1154 году на престол Генрих II продолжил строительство замка. С тех пор английские монархи не переставали считать его своей резиденцией.
В наши дни Виндзорский замок является самым большим из обитаемых замков в мире, ведь там работают и живут около 500 человек. Монарх там бывает в марте-апреле и неделю в июне каждого года, там он проводит церемонии, относящиеся к ордену Подвязки. Здесь же он официально принимает иностранных представителей. Каждый год в Виндзор приезжает примерно миллион туристов.
Самый белоснежный замок
Замок Химэдзи, Химэдзи, Япония
Летящий, словно ажурная вуаль, замок — один из древнейших сохранившихся в Японии. Он находится в живописном месте — в долине, у подножия горы Химэ.
Его название переводится как «замок Белой цапли», которое он получил за «особую отточенность форм и элегантность, напоминающую прекрасную белоснежную птицу». Он представляет собой огромный комплекс, состоящий из 83 зданий и занимающий площадь 220 000 м². Свой современный вид самурайская резиденция приобрела в начале XVII века. Эти сооружения удивительным образом не пострадали, выстояв во время войн и землетрясения. Неоднократно на территории замка Химэдзи проходили киносъемки. Например, здесь снимали фильмы «Ран» и «Тень воина» Акиры Куросавы. За красоту белоснежных деревянных стен, уникального сада, изогнутых линий крыши замок удостоили звания жемчужины Японии и внесли в список культурных ценностей ЮНЕСКО.
В следующем выпуске Выдающиеся водопады!
Мне уже многие указывали на появляющиеся неточности, я нашел выход. Вы можете ЗАРАНЕЕ просмотреть и прокомментировать весь материал. Я его теперь предварительно выкладываю в Телеграм. Одна голова хорошо, а две - лучше, значит и контент для Пикабу повысится качеством.